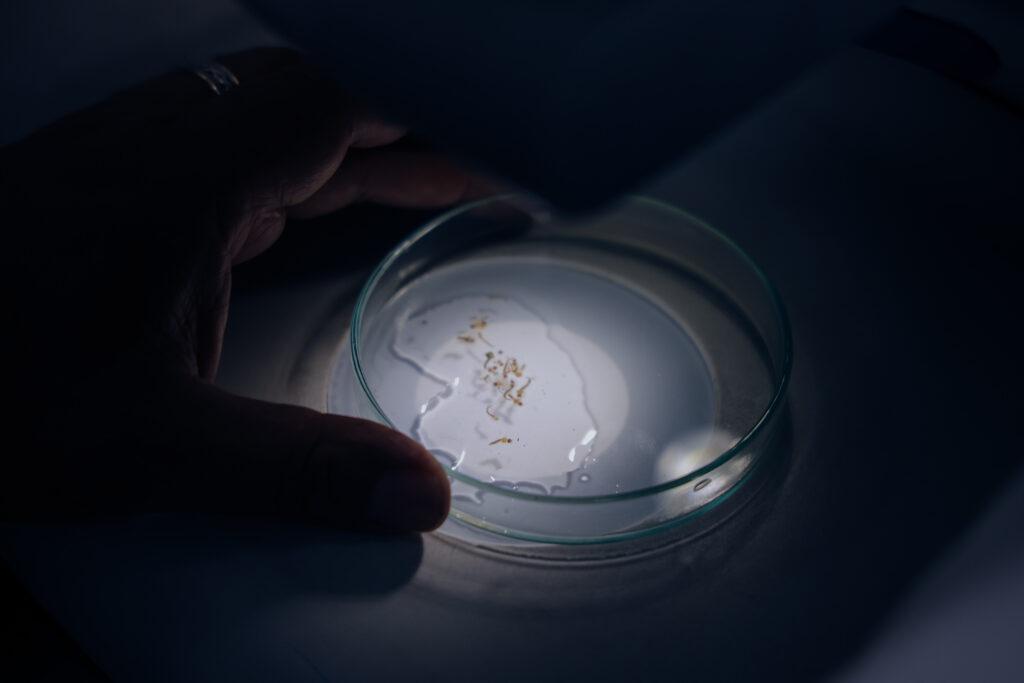

Connect with us
Published
1 año agoon

Con un proyecto conjunto se desarrollarán estrategias innovadoras para reducir la incidencia de contagios en Jalisco
Como parte de un esfuerzo conjunto para el desarrollo de estrategias innovadoras en el control biológico del mosquito transmisor del dengue, la Secretaría de Salud Jalisco (SSJ), anunció la incorporación de Kelly Diane Padilla Plascencia, estudiante del Colegio de Estudios Científicos y Tecnológicos del Estado de Jalisco (CECyTE), a la Unidad de Investigación Entomológica y Bioensayos del OPD Servicios de Salud Jalisco.
Padilla Plascencia fue reconocida a nivel internacional por su proyecto “Sin Dengue”, que presentó en la Feria de Ciencias de Atarfe, celebrada en marzo en Granada, España, donde fue nombrada embajadora global del conocimiento científico.
Su propuesta consiste en el diseño de un nanopolímero proteico que simula la piel humana, atrayendo al mosquito Aedes aegypti e incorporando la bacteria Wolbachia, conocida por su capacidad para reducir la transmisión del virus del dengue de manera segura para los seres humanos.
En un recorrido por las instalaciones de esta Unidad, Héctor Hugo Bravo Hernández, Director General del OPD Servicios de Salud Jalisco, reconoció el trabajo de todo el equipo a favor de la salud de la población.


«Como jaliscienses debemos sentirnos muy orgullosos. Primero de tener un gran equipo en esta Unidad de Investigación Entomológica, todo lo que se ha logrado y todos los retos que vienen para Jalisco, (…) el orgullo que sentimos de estar trabajando en tecnología (…) para que esto siga creciendo para poder evitar muertes por una enfermedad como el dengue”, comentó Bravo Hernández.
Kelly Diane explicó que su proyecto busca reducir la población del mosquito transmisor mediante un enfoque biotecnológico. “Mi proyecto se basa en la simulación de la piel con todos los factores atrayentes del mosquito Aedes aegypti y la bacteria Wolbachia, integrada para la erradicación de dicho virus».
La SSJ reafirma su compromiso con la ciencia y la innovación como herramientas fundamentales para enfrentar los retos sanitarios del estado. Este proyecto no solo busca tener un impacto positivo en la salud pública de Jalisco, sino convertirse en un modelo replicable a nivel nacional e internacional.

Para saber más:
La Unidad de Investigación Entomológica y Bioensayos de Jalisco se inauguró en 2024 y es la primera en todo México diseñada para las acciones de bioensayos y reforzamiento de las estrategias contra enfermedades causadas por vectores y zoonosis.


Reconoce Gobierno de Jalisco vocación y excelencia del personal de enfermería en el estado


Refuerzan municipios de Jalisco vacunación contra el sarampión


Jalisco refuerza acciones contra el sarampión con nuevos macromódulos y búsqueda activa de casos


Inicia campaña de vacunación contra el sarampión en la Universidad de Guadalajara


Realiza Cetrajal 4º Congreso de Donación y Trasplantes de Órganos y Tejidos


Anuncia Gobierno de Jalisco el proyecto Casa Compasiva, espacio para la atención de personas con enfermedades en etapa terminal







